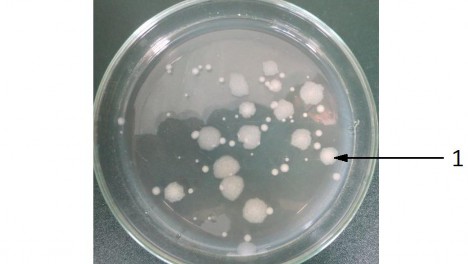
Hình 3 1 Hình dạng khuẩn lạc Bt trên môi trường MPA sau khi nuôi ở 28ºC sau 72h 2

EDTA, pH = 8.0: 10mM
Glucose: 50mM
Dung dịch Sol II: NaOH: 20mM.
SDS: 1%
Dung dịch Sol III: CH3COOK: 60ml CH3COOH: 11,5ml H2O: 28,5ml
Các dung dịch dung trong điện di trên gel agarose
Dung dịch TE: Tris HCl 10mM, pH= 8.0
EDTA 1mM, pH= 8.0
Dung dịch đệm điện di TAE 50X:
Tris base 121g
Acid acetic 5M: 28.6 ml EDTA 0.5M pH=8.0: 50ml
Nước khử ion đủ 500ml
Dung dịch đệm tra mẫu DNA (loading buffer) 5X:
Tris HCl 1M pH= 8.0: 1ml EDTA 0.5M pH=8.0: 2ml
Glycerol: 2ml Bromphenol blue 1%: 2ml
Gel điện di agarose 1%: agarose 1g, TAE 1X: 100ml
2.2. Phương pháp nghiên cứu
2.2.1. Phân loại các chủng Bt bằng phản ứng huyết thanh
Phương pháp phân loại Bt bằng phản ứng huyết thanh dựa trên đặc tính huyết thanh học của chủng Bt, nghĩa là dựa trên kháng nguyên tiêm mao H và được tiến hành bằng phản ứng ngưng kết các tế bào sinh dưỡng với kháng huyết thanh tương ứng. Phương pháp này cho phép xác định dưới loài Bt, tạo điều kiện thuận lợi cho việc lựa chọn các chủng Bt có hoạt tính cao với các bộ côn trùng. Các chủng Bt tham gia vào phản ứng ngưng kết huyết thanh phải là các chủng
có khả năng chuyển động. Do vậy, trước khi tiến hành phương pháp này, chúng tôi tiến hành kiểm tra khả năng chuyển động của các chủng nghiên cứu trên môi trường MT3 [30].
Cách tiến hành: các chủng Bt được cấy vào trong ống Craige (là ống thủy tinh nhỏ, được cắm thẳng đứng vào môi trường Craige chứa trong ống nghiệm to), nuôi ở 37ºC trong 24-28 giờ. Khi đó, những tế bào có khả năng chuyển động sẽ di chuyển lên phía trên bề mặt môi trường, giữa ống Craige và ống nghiệm. Vi khuẩn phát triển ở bề mặt này sẽ được cấy vào ống nghiệm có chứa 2ml môi trường MT2, lắc ở 70–75 vòng/phút trong khoảng thời gian 12-15 giờ [30].
Phản ứng ngưng kết với kháng huyết thanh tương ứng được quan sát trên kính hiển vi: lấy 2µl dịch nuôi nhỏ lên phiến kính lòm để kiểm tra khả năng chuyển động của vi khuẩn, sau đó nhỏ tiếp 2µl huyết thanh chuẩn (đã pha loãng) và quan sát dưới kính hiển vi.
2.2.2 Xác định mật độ bào tử Bt
Cấy các chủng Bt ra từng đĩa môi trường MPA riêng rẽ, nuôi ở 28ºC sau 3 ngày để thu sinh khối. Sinh khối vi khuẩn được xử lý ở 70ºC trong 10 phút, sau đó pha loãng đến nồng độ 10-8 lấy 100µl dịch ở mỗi nồng độ pha loãng 10-7 và 10-8 cấy thảm trên đĩa petri chứa môi trường MPA. Nuôi ở 28ºC trong 24h, đếm số khuẩn lạc mọc trên đĩa có nồng độ pha loãng nhỏ nhất. Số lượng bào tử được tính theo công thức:
CFU = n . a . 10
CFU: số lượng bào tử trong 1 ml dịch nuôi cấy.
n: số khuẩn lạc trung bình tạo thành trong 100µl dịch pha loãng a: nồng độ pha loãng.
2.2.3 Thử hoạt tính diệt côn trùng thử nghiệm
Để đánh giá khả năng tiêu diệt côn trùng bộ cánh vảy của các chủng nghiên cứu, chúng tôi tiến hành thử nghiệm trên đối tượng sâu xanh da láng (Spodoptera exigua) và sâu tơ (Plutella xylostella) theo phương pháp của Thiery và Frachon ở nồng độ 107 và 109 bào tử/ml đối với sâu xanh da láng và nồng độ
105 và 107 bào tử/ml đối với sâu tơ 105. Mỗi nồng độ thử nghiệm với 3 đĩa petri và mỗi đĩa 10 con sâu tơ và 3 con sâu đối với sâu xanh da láng [34].
Chuẩn bị:
Các chủng Bt được cấy thảm trên môi trường MPA, nuôi ở 280C trong 72 giờ. Sau đó, sinh khối được thu vào ống eppendorf chứa 1ml nước cất vô trùng. Pha loãng mật độ bào tử ở nồng độ 105 đến 107 bào tử/ml để thử hoạt tính.
Lá cải xanh hoặc lá bắp cải sạch (không phun thuốc trừ sâu, không sâu bệnh) rửa sạch và tráng qua bằng nước cất, để khô tự nhiên, cắt lá với diện tích đều nhau sao cho vừa đĩa petri. Nhúng lá vừa cắt vào dịch Bt đã pha loãng và để 10 phút cho hai mặt lá được ngấm hết dịch Bt, lấy ra để khô ở nhiệt độ phòng. Sau đó cho lá đã khô dịch vào các đĩa petri, mỗi đĩa thử 10 con hoặc 3 con sâu xanh da láng. Nuôi ở nhiệt độ phòng và nơi thoáng mát và theo dòi tỉ lệ sâu chết trong 3 ngày.
Tỉ lệ sâu chết được tính theo công thức Abbott:
A = (C – T)/C. 100
A: % sâu chết
C: số sâu sống ở mẫu đối chứng T: số sâu sống ở mẫu thí nghiệm.
2.2.4 Tách chiết DNA plasmid
- Nuôi vi khuẩn trong môi trường MPB ở 28°C, lắc 200 vòng/phút, qua đêm.
- Lấy 1,5ml dịch nuôi cấy ly tâm 6000 vòng/phút trong 10 phút, thu cặn.
- Bổ sung 150µl dung dịch sol I, vortex.
- Bổ sung 150µl dung dich sol II, đảo nhẹ bằng tay.
- Bổ sung 150µl dung dịch sol III, lắc mạnh cho tủa hòa tan.
- Ly tâm 10000 vòng/phút trong 10 phút, 4ºC, thu dịch nổi.
- Bổ sung 1ml cồn tuyệt đối
- Tủa ở - 20°C trong 4 giờ.
- Ly tâm 10000 vòng/phút trong 10 phút, thu tủa.
- Làm khô tự nhiên.
- Hòa tủa trong 35µl RNase, ủ ở 37°C trong 1h.
- Đẩy nước lên tới 500µl.
- Bổ sung chloroform: isoamylalcohol (24:1); tỷ lệ 1: 1, đảo bằng tay.
- Ly tâm 12000 vòng/phút trong 10 phút, 4ºC, thu dịch nổi
- Bổ sung NaOAC/KOAC, tỷ lệ 1: 10.
- Bổ sung cồn tuyệt đối, tỷ lệ 2,5: 1.
- Ủ ở -20ºC trong ít nhất 4h.
- Ly tâm 12000 vòng/phút trong 10 phút ở 4ºC, thu tủa.
- Rửa tủa bằng 200µl cồn 70º.
- Ly tâm 12000 vòng/phút trong 10 phút ở 4ºC, thu tủa.
- Làm khô, hòa tủa trong 35µl dH2O.
- Bảo quản ở - 20ºC .
2.2.5 Sàng lọc chủng Bt mang gene cry1C bằng PCR
Phương pháp PCR do Karl Mulis và cộng sự phát hiện năm 1985. Nhờ enzym DNA polymerase xúc tác, trên các mạch khuôn DNA tổng hợp nên các mạch đơn mới. Các mạch đơn mới được tổng hợp lại được sử dụng làm khuôn cho quá trình tổng hợp mạch mới ở chu kỳ tiếp theo. Sự tổng hợp mạch đơn DNA mới cần có sự tham gia của DNA mồi tạo các nhóm 3’-OH tự do. Các nucleotide được gắn ở vị trí nhóm OH tự do tạo thành mạch đơn mới.
Thành phần 1 phản ứng PCR: dNTPs 2µl
Đệm (có Mg2+) 2µl
Mồi 1C F 1µl
Mồi 1R 1µl
Taq polymease 0,2µl
DNA Temp 2µl
dH2O 11,8µl
Thể tích/phản ứng: 20µl
Sản phẩm PCR được kiểm tra bằng phương pháp điện di trên gel agarose 1%.
2.2.6 Tách dòng đoạn gene cry1C
Gắn sản phẩm PCR vào vector tách dòng pGEM-T Easy
Sản phẩm PCR được gắn trực tiếp vào vector tách dòng nhờ enzyme nối T4- DNA ligase.
Thành phần phản ứng gắn sản phẩm PCR vào vector tách dòng:
Đệm 5µl
Vector 1µl
T4-DNA ligase 1µl
Sản phẩm PCR 3µl Phản ứng ghép nối được tiến hành 14 - 16h ở 4ºC.
Biến nạp plasmid tái tổ hợp vào E. coli DH5α
Nguyên tắc: Dưới tác dụng của CaCl2 thành tế bào đang ở thời kỳ sinh trưởng trở nên xốp tạo điều kiện cho DNA có thể chui qua lỗ màng vào tế bào chất khi sốc nhiệt.
Quy trình gồm 2 bước
+ Chuẩn bị tế bào khả biến:
- Nuôi cấy 1 khuẩn lạc E. coli DH5α trong môi trường LB lỏng qua đêm.
- Chuyển 0,5ml dịch nuôi cấy tế bào qua đêm sang 50ml môi trường LB.
- Lắc 200 vòng/phút trong 2h ở 37ºC. Đo OD600 đạt 0,5-0,6 thì hút lấy mẫu vào ống eppendorf đặt trên đá 1h. Sau bước này mọi thao tác luôn phải được thực hiện ở 4ºC.
- Mẫu sau đặt đá 1h được ly tâm 6000 vòng/phút trong 10 phút, loại dịch nổi. Hòa tế bào thu được trong 1-1,5ml CaCl2 100mM vô trùng, vortex và ly tâm thu tủa ở 6000 vòng/phút trong 10 phút.
- Hòa tan lại tủa trong 1,5ml CaCl2 100mM, vortex, ủ mẫu trên đá trong 2h, cứ 15 phút đảo 1 lần.
- Ly tâm 6000 vòng/phút trong 10 phút ở 4ºC, hòa tế bào trong 60µl CaCl2 100 mM, bổ sung 15% glycerol.
- Bảo quản tế bào ở - 80ºC
+ Biến nạp:
- Lấy tế bào khả biến từ - 80ºC để vào đá 30 phút.
- Hút 5µl sản phẩm của phản ứng nối ghép gene vào dung dịch tế bào khả biến và trộn đều, để đá 30 phút (nhằm tạo cho hỗn hợp có một nhiệt độ thấp nhất định và tạo điều kiện cho vector tái tổ hợp tiếp cận tế bào một cách đồng đều).
- Sốc nhiệt ở 42ºC trong 60-90 giây sau đó giữ trong đá 2 phút.
- Bổ sung 200-300µl môi trường LB và lắc ở 37ºC, 200 vòng/phút trong 1- 1,5 giờ.
- Trải 150µl sản phẩm trên đĩa petri chứa môi trường LBA bổ sung ampicilin
+ X- gal, nuôi ở 37ºC từ 14-16h.
Sàng lọc khuẩn lạc bằng PCR colony
Các thành phần PCR colony tương tự như phản ứng khuếch đại gene cry1C với mồi đặc hiệu, chỉ khác ở chỗ khuôn DNA được thay thế bằng một lượng nhỏ sinh khối từ các khuẩn lạc trắng và sử dụng cặp mồi M13.
Tách DNA plasmid từ E. coli DH5α
Lấy khuẩn lạc vi khuẩn chứa plasmid tái tổ hợp (khuẩn lạc màu trắng) cấy vào 2ml môi trường LB chứa ampicillin, lắc qua đêm 200 vòng/phút ở 37ºC.
Qui trình tách tương tự như quy trình tách DNA plasmid của Bt Xử lý DNA plasmid bằng enzyme giới hạn EcoRI
Để xác định chính xác vector tái tổ hợp có mang đoạn gene mong muốn hay không, cắt đoạn DNA đã ghép nối vào plasmid bằng EcoRI.
Trình tự cắt của EcoRI:

Thành phần của phản ứng cắt:
Thể tích (µl) | |
DNA plasmid | 6µl |
Buffer | 1µl |
EcoRI | 0,5µl |
dH2O | 2.5µl |
Tổng thể tích | 10µl |
Có thể bạn quan tâm!
-
Nghiên cứu đặc điểm sinh học của một số chủng Bacillus Thuringiensis sinh Protein tinh thể diệt côn trùng cánh vảy - 1 -
Nghiên cứu đặc điểm sinh học của một số chủng Bacillus Thuringiensis sinh Protein tinh thể diệt côn trùng cánh vảy - 2 -
Mô Hình Cấu Trúc Không Gian 3 Chiều Của Protein Độc Tố Cry1Ac -
Gene Cry1C Và Dưới Loài Bacillus Thuringiensis Subsp . Aizawai -
Nghiên cứu đặc điểm sinh học của một số chủng Bacillus Thuringiensis sinh Protein tinh thể diệt côn trùng cánh vảy - 6 -
Nghiên cứu đặc điểm sinh học của một số chủng Bacillus Thuringiensis sinh Protein tinh thể diệt côn trùng cánh vảy - 7
Xem toàn bộ 63 trang tài liệu này.
Phản ứng cắt được tiến hành ở 37ºC trong 4h.
2.2.7 Xác định trình tự nucleotide
Tiến hành theo phương pháp tổng hợp của Sanger và CS. Thực hiện phản ứng PCR ngoài các thành phần thông thường còn bổ sung 4 loại dideoxynucleotide (ddATP, ddCTP, ddGTP, dd TTP) và được đánh dấu bằng thuốc nhuộm huỳnh quang [23].
Điện di sản phẩm PCR trên gel polyacrylamide bổ sung urea để tăng độ phân giải của gel. Sử dụng tia lase quét phát hiện dideoxynucleotide đã đánh dấu.
Xử lý kết quả bằng phần mềm PC/GENE, sau đó so sánh trình tự gene đã tách dòng với các trình tự đã công bố trong GenBank.
2.3 Địa điểm thực hiện đề tài
Đề tài được thực hiện tại phòng Di truyền vi sinh vật, Phòng thí nghiệm trọng điểm Công nghệ Gen, Viện CNSH, Viện Khoa học và Công nghệ Việt Nam
Chương 3. KẾT QUẢ VÀ THẢO LUẬN
3.1 Sàng lọc chủng Bacillus thuringiensissubsp. aizawai mang gene cry1C
có hoạt tính diệt sâu xanh da láng và sâu tơ
3.1.1 Phân loại hình dạng tinh thể của các chủng Bt nghiên cứu
Từ 150 chủng vi sinh vật thu nhận được sau 3 ngày nuôi cấy ở 280C, trên đĩa thạch chứa môi trường MPA mọc lên nhiều loại khuẩn lạc B. thurigiensis hình tròn, có màu trắng sữa và mép nhăn hoặc không (Hình 3.1).
Hình 3.1. Hình dạng khuẩn lạc Bt trên môi trường MPA sau khi nuôi ở 28ºC sau 72h (1: Khuẩn lạc Bt)
Từ mỗi đĩa nuôi cấy chúng tôi tách lấy một khuẩn lạc riêng rẽ làm tiêu bản với thuốc nhuộm fuchsin base sau đó quan sát trên kính hiển vi quang học ở độ phóng đại 1000X (vật kính dầu). Kết quả cho thấy trong 150 chủng vi khuẩn thuộc nhóm Bacillus cereus đã thu thập, có 54 chủng sinh tinh thể. Kết quả này được thể hiện trong Hình 3.2, Bảng 3.1.






